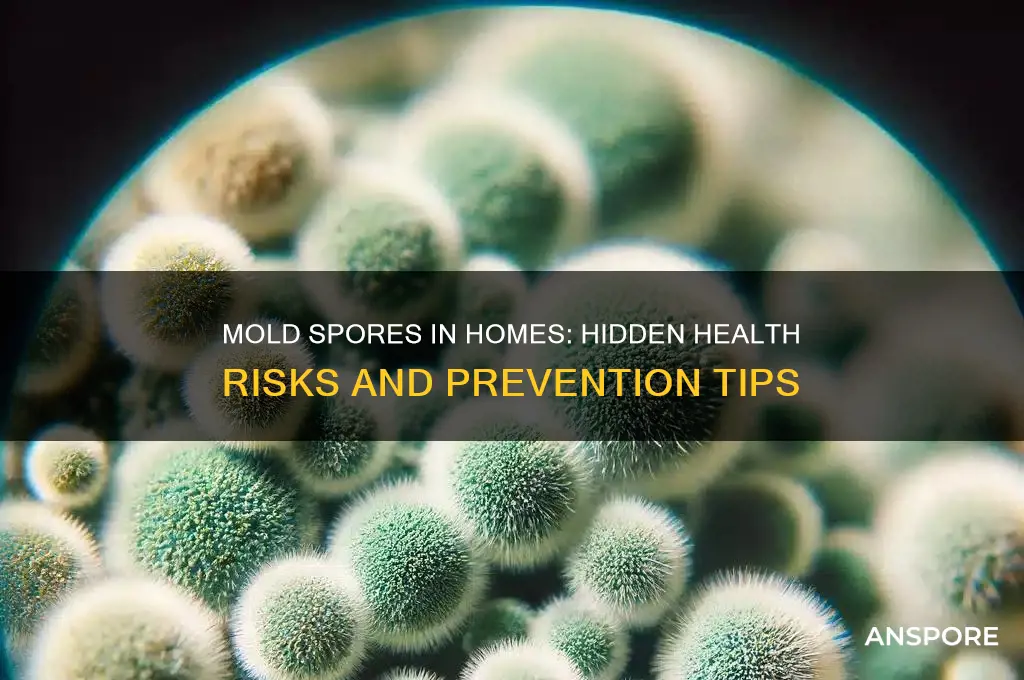
how does mole spores in a house affect your health

Mold spores in a house can significantly impact your health, as they release allergens, irritants, and in some cases, toxic substances called mycotoxins. Prolonged exposure to mold spores may trigger allergic reactions, such as sneezing, runny nose, and skin rashes, especially in individuals with allergies or asthma. Additionally, mold can irritate the eyes, skin, nose, throat, and lungs, leading to persistent coughing, wheezing, or respiratory issues. For those with compromised immune systems or pre-existing health conditions, mold exposure can cause more severe symptoms, including infections or exacerbation of chronic illnesses. Addressing mold growth promptly is essential to mitigate these health risks and maintain a safe indoor environment.
| Characteristics | Values |
|---|---|
| Allergic Reactions | Can cause sneezing, runny or stuffy nose, itchy eyes, and skin rashes in sensitive individuals. |
| Asthma Exacerbation | May trigger asthma symptoms such as wheezing, coughing, chest tightness, and shortness of breath, especially in asthmatic individuals. |
| Respiratory Infections | Prolonged exposure to mold spores can weaken the immune system, increasing susceptibility to respiratory infections like bronchitis or pneumonia. |
| Irritation of Eyes, Nose, and Throat | Mold spores can irritate mucous membranes, leading to redness, itching, and discomfort in the eyes, nose, and throat. |
| Headaches and Fatigue | Exposure to mold spores has been associated with headaches, fatigue, and difficulty concentrating in some individuals. |
| Hypersensitivity Pneumonitis | In rare cases, exposure to high levels of mold spores can cause a severe lung condition called hypersensitivity pneumonitis, characterized by fever, chills, and difficulty breathing. |
| Toxic Effects (Certain Molds) | Some molds, like Stachybotrys chartarum (black mold), produce mycotoxins that can cause more severe health issues, including neurological problems and internal organ damage, though this is rare in residential settings. |
| Long-Term Health Risks | Chronic exposure to mold spores may contribute to long-term health issues, including chronic sinusitis, persistent cough, and reduced lung function. |
| Vulnerable Populations | Children, the elderly, pregnant women, and individuals with compromised immune systems or pre-existing respiratory conditions are more susceptible to mold-related health effects. |
| Prevention and Remediation | Reducing indoor humidity, fixing leaks, and promptly removing mold can mitigate health risks associated with mold spores in the home. |
Explore related products
What You'll Learn
- Respiratory Issues: Inhaling mold spores can cause asthma, allergies, coughing, and other breathing problems
- Immune System Impact: Prolonged exposure weakens immunity, increasing susceptibility to infections and illnesses
- Skin Irritation: Direct contact with mold spores may lead to rashes, itching, or dermatitis
- Toxic Mold Risks: Certain molds produce mycotoxins, causing severe health issues like organ damage
- Mental Health Effects: Mold exposure links to anxiety, depression, and cognitive difficulties in some cases

Respiratory Issues: Inhaling mold spores can cause asthma, allergies, coughing, and other breathing problems
Mold spores are invisible intruders that can turn your home into a health hazard, particularly for your respiratory system. When inhaled, these microscopic particles can trigger a cascade of issues, from mild irritation to chronic conditions. The severity of the reaction often depends on the concentration of spores and the individual’s sensitivity. For instance, prolonged exposure to mold in damp areas like basements or bathrooms can lead to a buildup of spores in the air, increasing the risk of respiratory problems. Even low levels of exposure can affect vulnerable populations, such as children, the elderly, or those with pre-existing respiratory conditions.
Consider the mechanics of how mold spores impact the lungs. When you breathe in mold spores, they can settle in the airways, causing inflammation and irritation. This reaction is often immediate in people with allergies, manifesting as sneezing, coughing, or a runny nose. Over time, repeated exposure can exacerbate asthma symptoms, leading to more frequent attacks and increased reliance on inhalers. Studies show that indoor mold exposure is linked to a 30-50% increase in asthma development in susceptible individuals, particularly children. For those without asthma, chronic exposure can still lead to persistent coughing, wheezing, or a feeling of tightness in the chest, mimicking asthma-like symptoms.
Preventing mold-related respiratory issues requires proactive measures. Start by identifying and addressing moisture sources in your home, such as leaks, condensation, or flooding. Use dehumidifiers to maintain indoor humidity below 50%, as mold thrives in damp environments. Regularly clean areas prone to mold, like shower tiles and window sills, with a solution of bleach and water. If mold is already present, small patches (less than 10 square feet) can be cleaned by homeowners, but larger infestations should be handled by professionals to avoid spreading spores. Air purifiers with HEPA filters can also reduce airborne spores, though they are not a substitute for mold removal.
For those already experiencing respiratory symptoms, it’s crucial to limit exposure while treating the underlying issue. If you suspect mold is the culprit, consult a healthcare provider for allergy testing or respiratory assessments. In severe cases, immunotherapy or prescribed medications may be necessary to manage symptoms. Simultaneously, take steps to improve indoor air quality by ensuring proper ventilation, especially in kitchens and bathrooms. Avoid carpeting in humid areas, as it can trap moisture and spores. For families with children or elderly members, regular monitoring of indoor air quality using mold test kits can provide early detection and peace of mind.
Ultimately, the link between mold spores and respiratory issues underscores the importance of a clean, dry living environment. While not everyone will react to mold, its potential to cause or worsen breathing problems cannot be ignored. By understanding the risks and taking preventive steps, you can protect your respiratory health and create a safer home. Remember, mold doesn’t just damage walls—it can harm lungs, too. Act early, act decisively, and breathe easier.
Can Mold Spores Infiltrate Your Furniture? Prevention and Detection Tips
You may want to see also

Immune System Impact: Prolonged exposure weakens immunity, increasing susceptibility to infections and illnesses
Prolonged exposure to mold spores in a house doesn't just trigger allergies or respiratory issues—it systematically undermines your immune system. Mold releases mycotoxins, toxic substances that, when inhaled or ingested, can disrupt the body’s natural defense mechanisms. Over time, this chronic assault forces the immune system into overdrive, leading to a state of constant inflammation. This hyperactive response depletes immune resources, leaving the body less equipped to fend off pathogens like bacteria and viruses. Studies show that individuals living in mold-infested environments are 30-50% more likely to experience recurrent infections, from sinusitis to bronchitis, compared to those in mold-free homes.
Consider the mechanism at play: mold spores act as persistent irritants, triggering immune cells to release cytokines, signaling molecules that promote inflammation. While short-term cytokine release is protective, chronic exposure leads to cytokine fatigue, where the immune system becomes desensitized and less responsive. For instance, a 2019 study published in *Indoor Air* found that prolonged mold exposure reduced natural killer cell activity by 25% in adults, a critical component of the immune system’s first line of defense against infections. Children and the elderly, with developing or weakened immune systems, are particularly vulnerable. A child exposed to mold spores daily for six months may exhibit a 40% increase in respiratory infections, according to a 2020 *Environmental Health Perspectives* report.
To mitigate this risk, practical steps are essential. First, maintain indoor humidity below 50%—mold thrives in damp conditions. Use dehumidifiers in basements and bathrooms, and promptly fix leaks in roofs, pipes, or windows. Second, improve ventilation by opening windows, using exhaust fans, or installing air exchange systems. For existing mold, clean affected areas with a solution of 1 cup bleach per gallon of water, ensuring proper protective gear like gloves and masks. If mold covers more than 10 square feet, consult a professional remediation service, as DIY methods may not suffice.
Comparatively, the immune impact of mold exposure is akin to running a marathon without rest—eventually, the system collapses under the strain. Unlike seasonal allergens, which the immune system adapts to over time, mold spores introduce foreign toxins that continuously provoke an immune response. This distinction is critical: while allergies may cause discomfort, mold-induced immunosuppression can lead to life-threatening conditions like pneumonia or sepsis. For immunocompromised individuals, such as those with HIV or undergoing chemotherapy, even low-level mold exposure can be catastrophic, increasing infection risk by up to 70%.
The takeaway is clear: addressing mold isn’t just about improving air quality—it’s about safeguarding your immune system’s resilience. Regularly inspect hidden areas like crawl spaces, behind walls, and under sinks for mold growth. Invest in air purifiers with HEPA filters to capture spores, and consider annual HVAC system inspections to prevent spore circulation. By treating mold exposure as a systemic health threat, not just a nuisance, you can preserve immune function and reduce the likelihood of infections that exploit a weakened defense system.
Norovirus Spores: Fact or Fiction? Unraveling the Truth About Transmission
You may want to see also

Skin Irritation: Direct contact with mold spores may lead to rashes, itching, or dermatitis
Mold spores in the home are not just unsightly; they can directly trigger skin irritation upon contact. Unlike airborne exposure, which primarily affects the respiratory system, physical contact with mold spores can lead to immediate and localized reactions. For instance, touching mold-infested surfaces or handling contaminated items may result in rashes, itching, or dermatitis within hours. This occurs because mold spores contain allergens and irritants that disrupt the skin’s protective barrier, causing inflammation. Individuals with sensitive skin or pre-existing conditions like eczema are particularly vulnerable, as their skin is less equipped to withstand these irritants.
To mitigate skin irritation, it’s essential to identify and avoid direct contact with moldy materials. Wear protective gloves when cleaning mold-prone areas, such as bathrooms or basements, and ensure these areas are well-ventilated. If contact occurs, wash the affected skin immediately with mild soap and water to remove spores. Over-the-counter hydrocortisone cream (1% strength) can alleviate mild itching or redness, but consult a healthcare provider if symptoms persist or worsen. For children or the elderly, whose skin is more delicate, take extra precautions to prevent exposure, as their reactions may be more severe.
Comparatively, skin irritation from mold spores differs from other household irritants like detergents or fabrics. While detergents cause chemical burns or dryness, mold spores induce an allergic or inflammatory response. Unlike fabric irritants, which often require prolonged contact, mold spores can cause reactions after brief exposure, especially in susceptible individuals. Understanding this distinction helps in tailoring prevention strategies, such as using mold-resistant products or maintaining low humidity levels to inhibit mold growth.
Practically, prevention is key to avoiding skin irritation from mold spores. Regularly inspect and clean areas prone to moisture, such as under sinks, around windows, and in laundry rooms. Use a dehumidifier to keep indoor humidity below 50%, as mold thrives in damp environments. If mold is detected, address the source of moisture before cleaning to prevent recurrence. For extensive infestations, consider professional remediation to ensure thorough removal. By taking proactive steps, you can protect your skin and maintain a healthier living environment.
Exploring Moss Reproduction: Do Mosses Produce Two Distinct Types of Spores?
You may want to see also
Explore related products

Toxic Mold Risks: Certain molds produce mycotoxins, causing severe health issues like organ damage
Mold spores in a house are not just unsightly; they can be silent harbingers of toxic threats. Certain molds, such as *Stachybotrys chartarum* (black mold), *Aspergillus*, and *Fusarium*, produce mycotoxins—toxic compounds that, when inhaled or ingested, can wreak havoc on the human body. Unlike common allergens, mycotoxins are potent enough to cause systemic damage, particularly to organs like the liver, kidneys, and lungs. Prolonged exposure, even in small amounts, can lead to chronic conditions, making early detection and remediation critical for safeguarding health.
Consider the case of a family in Ohio whose home was infested with *Stachybotrys chartarum*. Over months, they experienced persistent headaches, fatigue, and unexplained respiratory issues. Medical tests revealed elevated levels of mycotoxins in their blood, correlating with liver enzyme abnormalities. This example underscores the insidious nature of toxic mold: symptoms often mimic common illnesses, delaying diagnosis. For vulnerable populations—children, the elderly, and immunocompromised individuals—even low-level exposure can escalate quickly, emphasizing the need for proactive mold management.
To mitigate toxic mold risks, start with a thorough inspection of damp areas like basements, bathrooms, and attics. Use a moisture meter to identify hidden water damage, as mold thrives in humidity above 60%. If mold is detected, professional remediation is advised, especially for areas larger than 10 square feet. DIY removal can disturb spores, increasing airborne toxin levels. Invest in HEPA air filters and dehumidifiers to maintain optimal indoor conditions. Regularly clean HVAC systems, as they can circulate spores throughout the house.
Prevention is equally crucial. Fix leaks promptly, ensure proper ventilation, and monitor indoor humidity levels. For those already exposed, medical intervention may include antifungal treatments, detox protocols, and organ function monitoring. Awareness and action are key—toxic mold is not just a structural issue but a health crisis waiting to unfold. By understanding the risks and taking preventive steps, you can protect your home and health from the silent menace of mycotoxins.
Spore's Social Tool: Boosting Tribal Stage Success or Just a Distraction?
You may want to see also

Mental Health Effects: Mold exposure links to anxiety, depression, and cognitive difficulties in some cases
Mold spores in a house can silently undermine mental well-being, with research increasingly linking exposure to heightened risks of anxiety, depression, and cognitive difficulties. Studies suggest that mycotoxins, toxic substances produced by certain molds, can cross the blood-brain barrier, triggering inflammation and disrupting neurotransmitter function. For instance, a 2019 meta-analysis published in *Environmental Research* found a significant association between mold exposure and depressive symptoms, particularly in individuals with pre-existing respiratory conditions. This isn't merely a physical health issue—it's a mental health concern that demands attention.
Consider the insidious nature of mold: often hidden behind walls, under floors, or in damp corners, it releases spores that circulate through the air, infiltrating the body via inhalation. Prolonged exposure, especially to toxic molds like *Stachybotrys chartarum* (black mold), can lead to chronic inflammation, which has been linked to anxiety disorders. A 2021 study in *Toxicology Reports* highlighted that individuals living in mold-infested homes reported higher levels of generalized anxiety compared to those in mold-free environments. The psychological toll is compounded by the stress of dealing with the mold itself, creating a vicious cycle of worry and deterioration.
Cognitive difficulties are another alarming consequence of mold exposure, particularly in vulnerable populations such as children and the elderly. Mycotoxins can impair memory, attention, and executive function by damaging neural pathways. A 2018 study in *Applied Ergonomics* found that students in mold-contaminated schools exhibited slower reaction times and reduced problem-solving abilities compared to their peers in cleaner environments. For older adults, mold exposure may exacerbate age-related cognitive decline, making it crucial to address mold issues promptly in homes and public spaces.
Practical steps can mitigate these risks. Regularly inspect your home for signs of mold, such as musty odors, water stains, or visible growth, especially in areas prone to moisture like bathrooms and basements. Use a dehumidifier to maintain indoor humidity below 50%, and ensure proper ventilation in high-moisture areas. If mold is detected, hire a professional remediation service to safely remove it, as improper handling can release more spores into the air. For those already experiencing mental health symptoms, consult a healthcare provider to rule out mold exposure as a contributing factor.
The link between mold and mental health is a call to action for homeowners, renters, and policymakers alike. While more research is needed to fully understand the mechanisms at play, the evidence is clear: mold spores are not just a nuisance—they are a potential threat to psychological well-being. By taking proactive measures to prevent and address mold growth, individuals can protect not only their physical health but also their mental resilience.
Spore Drive's Impact: Does It Harm the Mycelial Network?
You may want to see also
Frequently asked questions
Mold spores are tiny, airborne reproductive units produced by mold fungi. They can enter a house through open doors, windows, vents, or HVAC systems, and can also attach to clothing, pets, or other items brought indoors.
Mold spores can trigger allergic reactions, respiratory issues, and other health problems, especially in sensitive individuals. Symptoms may include sneezing, coughing, skin irritation, headaches, and asthma attacks.
People with allergies, asthma, weakened immune systems, infants, elderly individuals, and those with chronic respiratory conditions are most vulnerable to the health effects of mold spores.
Prolonged exposure to mold spores can lead to chronic respiratory problems, persistent allergies, and in rare cases, severe infections, especially in immunocompromised individuals.
To minimize health risks, control indoor humidity below 60%, fix leaks promptly, ensure proper ventilation, clean and remove mold growth, and use air purifiers with HEPA filters. Regularly inspect areas prone to moisture, such as basements and bathrooms.































